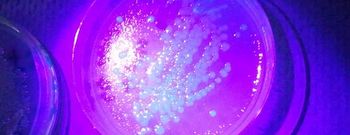

بحسب بحث جديد
التواصل داخل أدمغة النساء والرجال يتم بشكل مختلف
(د ب أ) - كثيرا ما يقال إن الرجال أفضل من النساء في بعض الأشياء مثل ركن السيارة بشكل مواز، في حين يقال إن النساء أفضل من الرجال في الأمور التي تتعلق بالمشاعر.
فقد وجدت دراسات سابقة أن المرأة تميل إلى أن تكون أفضل في التعاطف مع الأخرين بينما عادة ما يكون الرجل أفضل في ترتيب الأمور بشكل منهجي. لكن ظهرت حاليا أدلة متزايدة على أن التواصل بين أدمغة الرجال والنساء يتم في الواقع بشكل مختلف.
ويظهر بحث جديد نشر في دورية الاكاديمية الوطنية للعلوم في الولايات المتحدة الأمريكية "بي.إن.إيه.إس" أن التواصل الذي يتم داخل كل نصف دماغ على حده يكون على أفضل ما يكون في أدمغة الذكور. أما في أدمغة الإناث فيكون التواصل على أفضل ما يكون بين نصفي الدماغ.
ويعتقد الباحثون أن هذه الاختلافات التشريحية يمكن أن تفسر السبب في أفضلية الذكور من حيث القدرات الحركية والمكانية ، في حين أن الإناث لديهن مهارات ذاكرة أفضل كما أنهن أفضل في التعامل مع العلاقات الاجتماعية.
وعن طريق تقنية تعرف باسم "التصوير المنتشر المنقبض" ، تمكنت الباحثة مادهورا إنجالهاليكار وفريقها من جامعة بنسلفانيا في فيلادلفيا من تكوين فكرة متعمقة عن طريقة عمل الألياف العصبية داخل الأدمغة الحية من خلال رسم خريطة لعملية انتشار جزيئات الماء داخل المخ.
وفي عينة مؤلفة من 949 شابا تتراوح أعمارهم بين 8 و22 عاما( 428 من الذكور و 521 من الإناث)، قسم العلماء الدماغ إلى 95 قطاعا مختلفا واكتشفوا فروقا فريدة من نوعها بين الجنسين فيما يتعلق بالتواصل داخل الدماغ أثناء عملية التطور .
ويشير البحث إلى أن تشريح أدمغة الذكور يعد امرا جيدا لتنسيق ما بين مفهومي التصور والعمل ، مثل رؤية كرة وهي ترتفع ثم يتم التقاطها، في حين ان أدمغة الإناث مصممة للربط ما بين الأجزاء التحليلية والبديهية للفكر.
وفي دراسة سلوكية أجريت في وقت سابق تتضمن عينة أكبر ، اكتشف علماء أن النساء أكثر قدرة على تذكر الكلمات والوجوه وأكثر قدرة على ملاحظة الأشياء كما كان لديهن قدرات أكبر على الإدراك الاجتماعي ، في حين ان الرجال كان لديهم مهارات حركية ومكانية أفضل .
وقال الباحثون إن الفروق الملحوظة في الكيفية التي يتم بها التواصل داخل أدمغة الرجال والنساء قد تكون من بين الأسباب التي تقف وراء هذه الاختلافات السلوكية.